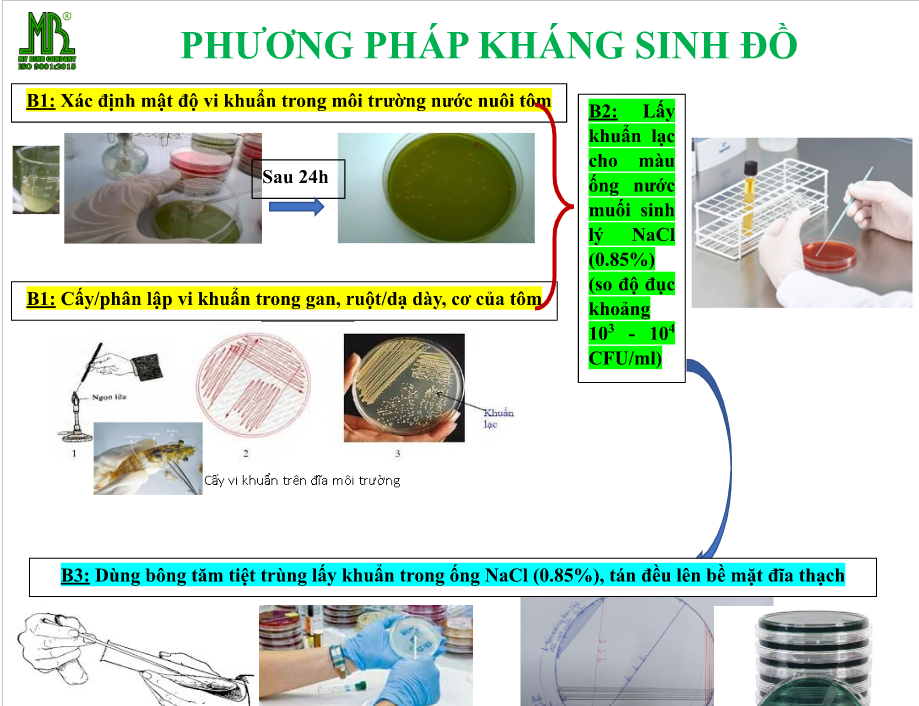
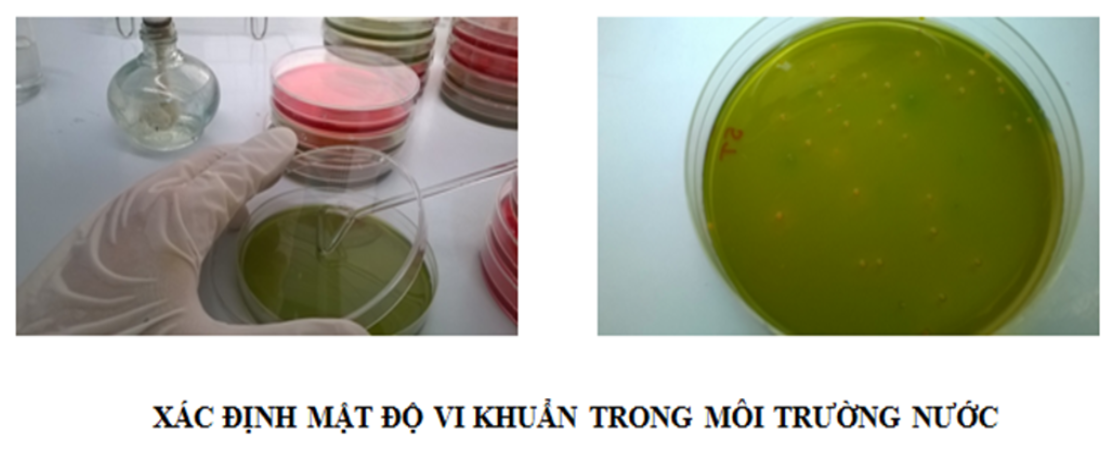

Phòng xét nghiệm bệnh tôm - Sự cống hiến miệt mài cho ngành nuôi tôm công nghệ cao
Tháng 4/2023 vừa qua, Các phòng xét nghiệm bệnh tôm của Công ty Mỹ Bình ở các tỉnh ĐBSCL đã hoàn thành 3928 lượt xét nghiệm cho Quý bà con nuôi tôm, đồng thời thống kê lại những trường hợp đáng chú ý ở mức báo động vàng cho một số tỉnh thành như: Cà Mau, Sóc Trăng, Bạc Liêu, Bến Tre, Long An, Trà Vinh.
Vì tình hình dịch bệnh đang diễn ra phổ biến và gây ảnh hưởng nghiêm trọng cho ao tôm ở một số tỉnh thành ĐBSCL có diện tích thả nuôi tôm lớn, nhận thấy được sự nguy hại từ dịch bệnh, Công ty Mỹ Bình đã kết nối và hỗ trợ trang thiết bị, dụng cụ cho Phòng xét nghiệm bệnh tôm tại các Đại lý của Công ty, nhằm phục vụ kịp thời cho bà con trong việc chẩn đoán bệnh, các vấn đề khác xảy ra trong ao nuôi, tránh được những sự cố đáng tiếc có thể xảy ra trong suốt quá trình nuôi.
Phòng xét nghiệm bệnh tôm của Công ty Mỹ Bình là nơi cung cấp các dịch vụ kiểm tra chất lượng nước và kiểm tra sức khỏe của tôm hàng ngày nhằm giúp người nuôi tôm đảm bảo năng suất và chất lượng tôm thương phẩm. Các kết quả kiểm tra từ phòng xét nghiệm bệnh tôm của Công ty Mỹ Bình sẽ cung cấp thông tin đầy đủ về tình trạng sức khỏe của tôm, mức độ ô nhiễm nước, sự xuất hiện của các bệnh tật và thủy sản độc hại, chất lượng thức ăn và các thông số khác cần thiết để quản lý môi trường ao tôm. Bên cạnh đó, Phòng xét nghiệm bệnh tôm còn giúp khách hàng thực hiện xác định loại kháng sinh có nhạy cảm với vi khuẩn và mức độ nhạy cảm đối với từng loại kháng sinh thông qua phương pháp kháng sinh đồ.
Phòng xét nghiệm bệnh tôm của Công ty Mỹ Bình lập kháng sinh đồ cho khách hàng
Từ đó, người nuôi tôm có thể đưa ra các quyết định nhanh chóng và chính xác về việc sửa đổi phương pháp nuôi tôm của mình để về size lớn mang lại lợi nhuận cao cho bà con. Do đó, vai trò của phòng xét nghiệm bệnh tôm là rất cần thiết trong việc chẩn đoán bệnh tôm, nâng cao hiệu quả sản xuất và bảo vệ môi trường nuôi tôm ở các tỉnh ĐBSCL.
Mẫu tôm được mang đi xét nghiệm
Thực hiện kiểm tra các chỉ tiêu môi trường từ mẫu nước ao của khách
Phòng xét nghiệm bệnh tôm của Công ty Mỹ Bình thường được trang bị đầy đủ các thiết bị và dụng cụ dùng trong quá trình xét nghiệm mẫu nước, mẫu tôm, mẫu tảo như các bộ test Sera để đo các chỉ tiêu môi trường, kính hiển vi để kiểm khuẩn và soi tươi mẫu tôm giúp xác định mật độ khuẩn trong khối gan tụy tôm, máy PCR để kiểm tra chỉ tiêu CT trong việc xác định tôm có dương tính với EHP hay không…và các loại thiết bị khác dùng trong phòng xét nghiệm bệnh tôm. Các nhân viên trong phòng xét nghiệm bệnh tôm thường là các chuyên gia về sinh học, hóa học và vật lý. Họ có kiến thức nền rất vững về xét nghiệm cũng như các kĩ thuật về nuôi tôm. Công việc của họ là đảm bảo rằng các kết quả kiểm tra, phân tích trả lại cho khách hàng từ phòng xét nghiệm bệnh tôm hoàn toàn đúng quy trình, đúng kĩ thuật, đúng tiêu chuẩn.
Một vài trang thiết bị phục vụ cho các xét nghiệm
Tháng 4/2023 vừa qua, Các phòng xét nghiệm bệnh tôm của Công ty Mỹ Bình ở các tỉnh ĐBSCL đã hoàn thành 3928 lượt xét nghiệm cho Quý bà con, đồng thời thống kê lại những trường hợp đáng chú ý ở một số tỉnh thành sau đây:
- Cà Mau (Đầm Dơi): ghi nhận nhiều ao nhiễm EHP bội nhiễm phân trắng, một số ao có trường hợp tôm bị teo gan, khuẩn sợi, ngoại ký sinh vẫn chưa hết hẳn trong ao, môi trường nước ao nuôi có khí độc cao, phèn xuất hiện nhiều. Đối với các trường hợp trên, khách hàng Mỹ Bình đã xử lý bằng một số sản phẩm sau đây: EHP ROY, K-WE (kháng thể), FIBA PLUS, PROLIV, PROLIN, MB01.
- Bạc Liêu: ghi nhận nhiều ao mật độ khuẩn rất cao, khí độc cao vượt ngưỡng cho phép, trường hợp tôm bị EHP ở khu vực này đã giảm và được kiểm soát tốt, các chỉ tiêu môi trường chưa ổn định trong đó bao gồm độ pH, Kiềm, NO2. Để xử lý các trường hợp này, khách hàng Mỹ Bình đã lựa chọn các sản phẩm như: O3, YUCCA 100, BRONOL, một số ao khách sau khi đã kiểm soát được EHP trong ao tôm vẫn duy trì dùng sản phẩm EHP ROY kết hợp K-WE nhưng với liều cho ăn phòng, tránh trường bội nhiễm EHP.
- Sóc Trăng (Mỹ Xuyên): ghi nhận nhiều ao thiếu khoáng, mật độ khuẩn trong ao cao, khí độc cao. Để giải quyết các vấn đề này khách hàng Mỹ Bình đã tin dùng các sản phẩm như: O3, SELEN K+, MB01, ECO-BIO
- Long An (Cần Đước): ghi nhận nhiều ao của khách bị nhiễm EHP, có ao hao một ngày 6-7kg tôm. Để khắc phục trường hợp này thì khách hàng Mỹ Bình đã dùng EHP ROY.
- Long An (Cần Giuộc): ghi nhận nhiều ao của khách tôm bị bệnh phân trắng, có tảo xanh nhiều. Để xử lý, khách hàng Mỹ Bình đã dùng sản phẩm PROLIN, K-WE (kháng thể), MB01, O3.
- Bến Tre (Ba Tri): ghi nhận nhiều ao tôm bị bệnh phân trắng. Khách hàng Mỹ Bình đã sử dụng PROLIN và PROLIV điều trị rất hiệu quả cho tôm.
- Bến Tre (Bình Đại): ghi nhận nhiều trường hợp ao bị khí độc cao, phèn nhiều, tảo dày đặc. Để quản lý môi trường nước ao tốt, sạch trong, khách hàng Mỹ Bình đã xử lý bằng sản phẩm như: O3, FIBA PLUS, ECO-BIO, BACTER GOLD.
- Trà Vinh (Châu Thành): ghi nhận nhiều trường hợp ao bị bệnh phân trắng, đốm đen. Để xứ lý trường hợp tôm bị bệnh phân trắng và bệnh đốm đen, khách hàng Mỹ Bình đã dùng PROLIN, PROLIV, K-WE, AVAKON.
Để biết được phòng xét nghiệm bên tôm gần nhất, Quý bà con vui lòng liên hệ số Hotline của công ty 0911 383 533 để được hướng dẫn và hỗ trợ. Công ty Mỹ Bình kính chúc Quý bà con nhiều vụ tôm trúng mùa được giá. Trân trọng kính chào.